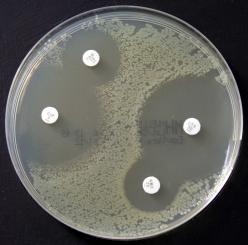
Mueller-Hinton - Agar
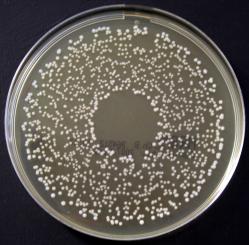
MRS-Agar
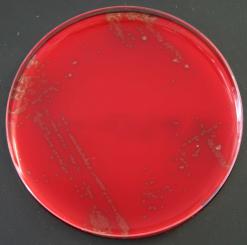
Columbia-Agar mit Schafsblut PLUS
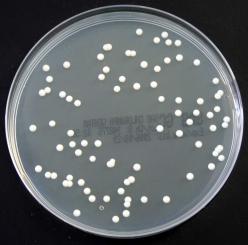
Sabouraud-Glucose-Agar mit Chlora. und Gentamicin
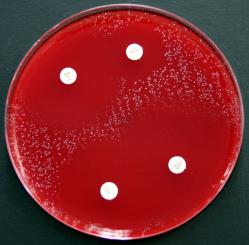
Mueller-Hinton - Agar mit 5% Schafsblut

8 Produkte
Sortieren nach:
BD CLED Agar (Cystine-Lactose-Electrolyte-Deficient Agar,...
12,80
€*
VPE: 20 Stück
Agar zum Anzüchten von Pilzen (Candida albicans), niedri...
17,25
€*
VPE: 20 Stück
Entspricht den internationalen Standards für Testmedien ...
5,20
€*
VPE: 10 Stück
Agar zur Isolierung und Kultivierung von Mikroorganismen ...
5,50
€*
VPE: 10 Stück
Agar für die Isolierung von Hefen und pathologischen Pil...
5,25
€*
VPE: 10 Stück
Entspricht den internationalen Standards für Testmedien ...
5,50
€*
VPE: 10 Stück
Candida Selektivagar nach Nickerson: Zur Isolierung und D...
17,05
€*
VPE: 20 Stück

 Deutsch
Deutsch